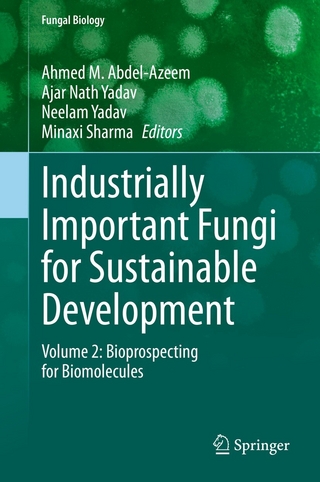
Industrially Important Fungi for Sustainable Development

Theories and Techniques
eBook Download (PDF)
2021
|
Springer Singapore
ISBN: 9789811639937
223,63 €
(CHF 218,45) (inkl. MwSt)
(CHF 218,45) (inkl. MwSt)
- Download sofort lieferbar